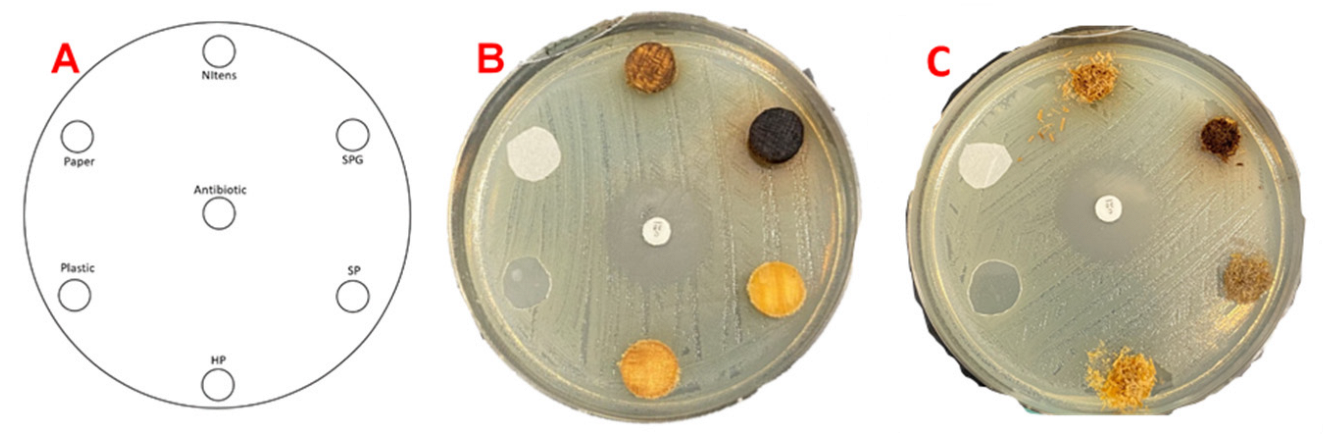
Forests 13 00334 g001

Abstract
The antimicrobial characteristics of Australian commercial timber species were studied using a direct screening method and two different microorganisms. The effectiveness of timber samples was compared with plastic and paper samples during an incubation period of 24 h at 37 °C. The initial data with E. coli and S. aureus showed no difference in performance between the plastic and paper samples and the softwood samples tested. Hardwood samples, however, showed an inhibition zone when tested with S. Aureus. The data showed similar trends of inhibition zones developed for sterilised and non-sterilised samples of spotted gum and shining gum species. The observed data showed promising antimicrobial characteristics for both veneer and solid samples of hardwood species. Further studies investigating the type of extractives, their role in antimicrobial characteristics and differences in the type of surface exposed to the microbial contamination from the point of view of timber’s anatomical properties are proposed.
1. Introduction
There is an increasing consumer demand to move away from traditional food packaging systems because they are generally non-renewable, less sustainable and have other disadvantages [1]. Internationally, many European countries currently favour wood-based packaging systems, especially for premium food products, due to the many environmental and health benefits [2]. Australia is uniquely positioned with a significant, sustainably managed, and certified plantation estate, and the Australian hardwood species are known for their high extractive content, durability, and strength. Whilst a significant wood food packaging industry exists in other parts of the world (the European Federation of Wooden Pallet and Packaging Manufacturers), in Australia the use of alternative food packaging to plastics is a relatively new trend.
1.1. Environmental and Economic Benefits
Forty per cent of materials used for food packaging end up in landfills, estimated to be 9 million tonnes of plastics added to the soil, 32% leaking out to our water resources and environment [3]. In 2017–2018, 274 thousand tonnes of soft scrunchable plastics were consumed in Australia, and only 1% of that was recovered, while 10% leaked to the environment and 89% ended up in landfills [4]. In Australia, from 58 thousand tonnes of disposable food packaging in 2017–2018, 15% was recovered while 11% leaked into the environment and 74% was released in landfills [4].
Up to 90% of the plastics used currently for food packaging can be replaced with another environmentally sustainable material [3]. Wood has been traditionally used for food packaging; however, the trend toward using other materials such as plastic and non-natural materials for use in the food industry has overshadowed the potential advantages that wood-based packing options can provide. Investigations on the properties of wood for food packaging have shown hygienic properties when manufacturing quality, handling operations, and appropriate treatment have been considered [5]. Wood-based food packaging options have been mainly designed and manufactured using timber species such as pine and poplar, while other species such as birch, lime and maple have also been used [6]. Interestingly the energy needed to produce wood-based packaging is much less than (1/30 times) what is required for plastic packaging production. Besides the lower energy required for manufacturing and the lower greenhouse gas production, timber-based packaging options are recyclable, compostable/biodegradable and not harmful if released in a landfill.
1.2. Timber Properties
Some timber species’ unique chemical composition provides potential durable characteristics and properties that are beneficial for use in industries such as food and beverage, confectionery, flavourings, medicines, cosmeceutical and nutraceutical, wood preservation, paints or polishes, adhesive applications and sanitising chemical production [1,2,7,8,9,10,11,12]. It has been well documented that these unique chemical compounds within timber can naturally possess the ability to be antimicrobial/bacterial [13,14,15,16,17,18,19,20,21,22,23,24,25]. These antimicrobial properties, the renewability of timber, and its physical characteristics allow it to be considered a potential material for food packaging.
Wood is comprised of four main components, namely cellulose, hemicelluloses, lignin, and extractives. The term wood extractives is defined as a range of chemical components with neutral and/or acidic characteristics that are extractable from timber using different types of organic solvents. However, there are also water-soluble compounds such as sugars that are also classified as extractives [13]. The above components vary greatly within different species of woods and also within the different sections of the tree itself. Within different parts of wood [26], sapwood contains significantly less lignin and more cellulose than heartwood; however, they both contain the same number of hemicelluloses. Other factors such as geographical areas, the age of the trees, growing conditions, and seasonal variations can affect the extractive content and the types of timber species [13]. The two main components that affect the antibacterial properties of the surface of the wood appear to be extractives and lignin.
The application and benefits of using different timber species for food packaging and serving have been studied over the years [1,2,7,8,9,10,11,12]. However, the investigation of Australian commercial timber species and their potential application for the food industry have not been fully researched. This paper presents the outcomes of a feasibility study on the potential application of timber species and products such as veneer, solid timber, and sawdust in food packaging. The project also aims to identify future directions and suggestions for further work in various areas, including a focus on different types of packaging, and investigate the effects of different food items with different moisture level on packaging surfaces.
2. Materials and Methods
2.1. Materials
In this study, four Australian commercial timber species, namely, hoop pine (Araucaria cunninghamii), southern pine (a hybrid between species: Pinus elliottii and Pinus caribaea), shining gum (Eucalyptus Nitens) and spotted gum (Corymbia citriodora) were used. All samples were conditioned to 12% moisture content in a conditioning chamber. The sterilisation of samples was completed at 25 kGy (using isotope Cobalt-60 according to ISO13485) [22,24].
Two types of bacteria were used—E. coli (Escherichia coli), Gram-negative and S. aureus (Staphylococcus aureus), and Gram-positive—in the direct screening method to examine the timbers’ susceptibility and resistance to microorganism growth. The selected microorganisms are commonly reported as a source of infections in both humans and animals. They are known for their resistance to a range of antimicrobials; however, they are also safe and manageable for the researchers to use in an experimental trial [27]. The broths were prepared using a 24 h old culture mixed in saline solution to a 0.5 Macfarlane standard, which is outlined in Section 2.2 below. Mueller–Hinton agar plates were used for the disc diffusion method.
To monitor the potential antibacterial characteristics of the tested species, a 6 mm chloramphenicol (30 µg) antibiotic disk was used to show the complete bacteria resistance and the uniform zone of inhibition. The next non-wood sample on the agar plate was plastic: given that the aim of this project was to investigate the natural antimicrobial ability of timber compared to plastic, a plastic sample was needed. Finally, a sterilised paper filter was also placed on the plate as another control.
2.2. Methods
Solid and veneer disk samples of the four wood species were prepared using a drill press with a 12 mm hole saw bit. Samples were approximately 3 mm thick and 11 mm in diameter. The disks of the solid and veneer samples were then placed into ziplock bags. The remaining offcuts from the disks were used to create the sawdust in a grinder with a mesh size of 1 mm; however, some fragments smaller and larger than this were observed. The amount of sawdust needed was the equivalent weight of the disks. After all the wood samples were created, the control specimens were prepared, which for this investigation were plastic (polypropylene takeaway container), paper filter, and a 6mm chloramphenicol (30 µg) antibiotic disk. All screening tests were repeated three times for timbre species, plastic, and paper sections. The sterilisation was performed on half of the prepared samples using 25 kGy gamma irradiation. The rest of the samples were kept non-sterilised and tested separately to investigate the effects of sterilisation on the antimicrobial characteristics of the samples. Cultures of both E. coli and Staph. aureus were prepared and placed into an incubator at 37 °C for 24 h before the experiment was conducted. On the day of the experiment, the MH agar plate was brought to room temperature in a 30 °C oven for 15 min before the plate was inoculated. The plates were put into a low-temperature oven to avoid condensation when reaching room temperature as they had been stored in a refrigerator. Tools and equipment such as tweezers were also sterilised using ethanol and a Bunsen burner (flaming technique) [22].
The inoculum was prepared on the day of the experiment using the culture prepared 24 h earlier. The absorbance of the solution was tested in a spectrophotometer, ensuring that the reading was between 0.08–0.1 @ 600 nm (this is the equivalent of 0.5 on the Macfarlane standard). The inoculation of the plates was performed using disposable sterilised cotton tips.
The samples were then removed from the vacuum-sealed bags and placed on the agar plate in the planned order and orientation shown below in Figure 1.
Figure 1.
(A) Diagram of the sample (SPG: spotted gum; SP: southern pine; and HP: hoop pine) set up. (B) Example petri dish used for direct screening method of disk samples. (C) Petri dish used for sawdust samples.
The sawdust was placed into the wells using a small spatula (shown in Figure 2C). The amount of sawdust used was enough to fill the well slightly above the surface. After this, the sawdust was compacted inside the well to sit level with the top of the agar plate and not mounded over. Immediately after each plate was finished (all samples placed on it) it was placed into an incubator set to 37 °C. The plates were left in the incubator undisturbed for 24 h as the bacteria grew. After the 24 h period passed, each plate was removed from the incubator individually, placed on a backlight, and a photo was taken.
Figure 2.
(A) Solid disc samples with E. coli; (B) Veneer disc samples with E. coli; (C) Sawdust samples with E. coli.
3. Results and Discussion
The results from the E.coli screening showed no visible difference between the wood samples and the plastic or paper samples tested. As previously investigated [22,24,25,28,29], there were no antibacterial effects against E. coli from any timber species in the direct screening test. As shown in Figure 2, the only material to produce an inhibition zone against E. coli was the antibiotic disc, while the plastic, paper, and timber samples showed no resistance activities.
The Gram-negative characteristics of E. coli could be the cause of what was observed in this stage of the testing. Similar trends were reported previously with no signs of resistance to antibiotics/microbial of Gram-negative bacteria in comparison with the Gram-positive bacteria [30]. Gram-negative bacteria have an outer membrane that the antimicrobials must pass through to attack the bacteria. Because of the lack of this outer layer in Gram-positive bacteria, more of the tested timber species were able to provide resistance against S. aureus than against E. coli [24,30]. The direct screening method described above is accurate in detecting a material’s ability to completely inhibit the growth or cell count of a bacterium, but it does not investigate the effect the material has on the bacterium’s life span. A 2005 study analysing the antimicrobial abilities of wood species including Larch, Pine, Beech and Maple using direct application methods and bacterial cell extraction and count showed that all timber species tested were able to reduce the cell count/life span of E. coli and E. faecium [10]. Further investigation using other methods of monitoring is suggested to investigate the potential resistance to E. coli using heartwood and sapwood samples with different levels of extractive contents.
Similar to the results observed for E. coli above, both the paper filter and the plastic container samples showed no resistance to microorganism growth with respect to S. aureus. Staph aureus is a Gram-positive bacterium with a large, porous peptidoglycan outer layer, making it more susceptible to antibiotics/antibacterial properties than Gram-negative bacteria. This increased susceptibility to antibacterial substances allows materials that naturally possess antimicrobial properties such as timber to inhibit growth (see Figure 3). A study [31] on the survival (number of days) of S. aureus and other Gram-positive bacteria on fabric and plastic found that all the bacteria survived between 5 and 10 times longer on plastic than fabric (cotton, terry polyester). The study inoculated each material sample and recorded whether the bacteria were still present every day for 90 days. On cotton, S. aureus survived between 4–21 days, and on plastic, the same bacteria survived between 22 and >90 days. This study investigated the effects of growth, without considering the potential role of the existence of more than one microorganism per surface. Future work is suggested to investigate the single microorganism growth using a more controlled and precise method [31].
Figure 3.
Samples of hardwood discs with inhibition zone (as shown by pointing arrows) after 24 h at 37 °C (a) shining gum—veneer, (b) shining gum—solid, (c) SPG—veneer, and (d) SPG—solid.
However, the study presented here investigated the effects of one microorganism growth at the time. Among the timber species tested in the current study, hardwood samples of both spotted gum and shining gum showed resistance to microorganism growth. Given this, only shining gum and spotted gum are analysed below.
The results on hardwood species for S. aureus showed antibacterial inhibition zones present, as shown in Figure 4. From the results above, shining gum and spotted gum showed higher antimicrobial potential than hoop pine and southern pine [32]. It is also possible that the concentration of extractives within each sample had an effect on its antimicrobial ability. A previous study using the disk diffusion method on resistance of wood species in contact with microbial contamination reported high antimicrobial characteristics of oak (Querceus spp.). This study examined a range of tile surfaces for use in a hospital environment. The study outcomes indicated that oak tiles were significantly more resistant to microbial contamination than stainless steel, high-density polyethylene, and plastic tiles. The inhibition zone reported for 9 mm discs were from 17.8 to 20.6 mm [22,24,25,28,29,33].
Figure 4.
Average inhibition zone sizes of different preparation methods, including cut type and sterilisation for S. aureus.
Overall, the solid and veneer samples exhibited similar trends in the number of positive results and inhibition zone size (Figure 5). It was initially hypothesized that solid and veneer surfaces might have slightly different results as timber is an orthotropic material, and its processing method (sawing, peeling, etc.) can expose different cells and therefore extractives. The effects of exposed surface type to bacteria and the potential effects of timber’s porous characteristics in delaying bacterial contamination has been studied previously [22,24,25,28,29,33]. A previous study [22] investigated the effect of transversal and tangential section cutting on timber’s antimicrobial properties. Very few species that were tested showed a difference based on the cut type and exposure surface. It is believed that the reason transversal cuts showed slightly better antimicrobial results is due to the arrangement of cells in timber: cutting transversely meant more surface area and resin was exposed. When more surface area has been exposed, the extractives in the wood are allowed to diffuse into the agar more. However, this was out of the scope of the present study and is considered one of the future directions and suggestions for further investigations.
Figure 5.
Average inhibition zones after more repetitions of the tests for the hardwood species tested.
The sawdust samples for shining gum and spotted gum species that had previously shown inhibition for solid and veneer showed no inhibition zone. In this study the sawdust samples were placed in wells cut into the agar plates. The potential differences between the samples exposed to the agar surface (rather than being placed in a well) and the surface area of exposure could be the reason for the lack of inhibition zone development. The sawdust was packed tightly into the well to produce a flat surface similar to that of the solid and veneer disks; however, given the size of the sawdust particles (≈1 mm), this was not completely achievable. The arrangement and surface contact type of sawdust might have impacted the sample resistance by reducing the contact area between the sawdust and the cylinder edge of the agar well. The quantity of sawdust placed into the well could also have impacted the testing outcomes. The original goal for the experiment was to use the same weight of sawdust as the average weight of the discs. However, even when compressing the sawdust to be as dense as possible the weight was just 20–30 mg compared to that of the disks, which averaged 150–350 mg depending on the species.
Further investigations into this deviation in results between the sawdust and solid samples are needed to fully determine what happened. Placing the sawdust in wells may have limited or changed the exposure of the antibacterial properties of the wood due to the type of contact and surface area. A previous study on direct screening of antimicrobial properties of untreated timber [10,22,24] showed that European oak (Quercus spp.) sawdust developed inhibition zones when in contact with S. aureus bacteria. However, it should be noted that they did not investigate the size of inhibition zones as the bacterium was placed directly onto the surface, and the survival time was measured. The same study reported inhibition zones for European fir, American oak, and European oak solid discs when in contact with S. aureus and no resistance to E.coli [22,24,25,28,29].
To study the potential effects of sterilisation, a batch of non-sterilised timber samples was included in testing. The results showed that sterilising the samples under gamma irradiation did not have an impact on whether a species, in general, was able to inhibit the growth of the bacteria. However, it did appear to have an effect on resistance to microorganism growth for the number of samples within the first round of tests. This was evident in the non-sterilised shining gum veneer test for S. aureus, where only one of the three repetitions showed an inhibition zone, whereas the same test for sterilised showed three out of three. Considering that there are multiple other reasons for a false positive or negative result, more repetitions are suggested to verify this data in future research. In the later part of this experiment, more repetitions of the test were conducted, and this allowed for the conclusion that sterilisation did not affect the results. The inhibition zone sizes are shown in Figure 5. There was a 1–6% variation in size between the sterilised and the non-sterilised samples. It should also be noted that even though the antibiotic discs were all sterilised, it appears that when they were used in the non-sterilised test the inhibition zones around them were slightly smaller than those in the sterilised test. Over the span of all repetitions, the average zone size of the antibiotic disks was 25.98 mm for the non-sterilised tests and 27.57 mm for the sterilised tests. Given that this is less than a 6% variation in zone size, it was concluded that the antibiotic disc was not affected by the environment (sterilised or non-sterilised) into which it was placed.
4. Conclusions and Future Work
This report focused on feasibility testing for the potential resistance of timber species in contact with two common bacteria, Escherichia coli (E. coli) and Staphylococcus aureus (S. aureus), using the direct screening method. The tested hardwood species, spotted gum and shining gum, showed antibacterial abilities when tested on S. aureus but not for E. coli. The two softwood species hoop pine and southern pine followed the same trend for both E. coli and S. aureus, which was no resistance with the direct screening method. Further testing using other monitoring and analytical methods is suggested. Given the physical properties of E. coli, it is a much more difficult bacterium to penetrate and kill compared to S. aureus. The plastic and paper filter samples showed no inhibitory ability against either bacterium. The inhibition zone measured showed that both sterilised and non-sterilised samples of untreated hardwood timber samples had some antibacterial properties. The preliminary results from the hardwood testing against S. aureus were investigated with respect to sterilisation, anatomy, and cut/processing type. Sterilisation did not affect the inhibition zone size as there was only 1–6% variation in average zone size between sterilised and non-sterilised. It was found that sawdust samples showed no zones of inhibition despite previous studies indicating that it would. This was most likely due to either the weight of sawdust used compared to the solid disks or the reduced surface contact area between the sawdust particle and the agar plate due to the well. Veneer and solid disc samples followed the same trends, so that based on the data set and replication conducted in this study there was no difference in anti-microbial properties between these two timber types representing different processing methods. The following future work is suggested according to the findings of this feasibility study:
- -
- Investigating the effect of species/anatomy on the rate of bacterial growth, potential contamination delays due to the porous structure of the timber, type of cell (size, frequency, density, shape, etc.) and the species chemistry and level of extractives.
- -
- Study of the potential effects of heartwood versus sapwood exposed to the contamination and their possible differences in different species.
- -
- Investigating the effects of timber surface roughness (smoother and rougher) given that there are studies showing that the roughness of a surface that microorganisms contact could influence the rate and scale of growth. Additionally, the potential effects of surface finishes and the roughness variations between plastic and timber surfaces needs to be investigated for Australian timber species. Previous studies have shown great potential for a lower survival rate of bacteria on timber surfaces in comparison with smooth plastic surfaces in a hospital environment [14,34].
- -
- Using different monitoring methods that could provide opportunities to observe the pattern and rate of growth and the survival rate of bacteria on the wood surface needs to be studied.
- -
- The advantages of using timber in terms of breathability and moisture management as well as any potential leaching issues from and to wood sections for different food products will also need to be considered as a future direction.
Funding
This project was funded by the Department of Agriculture and Fisheries, Queensland Government, Australia.
Institutional Review Board Statement
Not applicable.
Informed Consent Statement
Not applicable.
Acknowledgments
The authors of the report would like to thank Jake Kennedy for his contribution to the experimental work and data collection, and Andrew Cusack and Margaret Currie from the Agri-food and Data Science team at the Queensland Department of Agriculture and Fisheries for their assistance in laboratory work preparation and the testing process.
Conflicts of Interest
The authors declare no conflict of interest.
References
- Mendes, A.C.; Pedersen, G.A. Perspectives on sustainable food packaging:–is bio-based plastics a solution? Trends Food Sci. Technol. 2021, 112, 839–846. [Google Scholar] [CrossRef]
- Aviat, F.; Gerhards, C.; Rodriguez-Jerez, J.-J.; Michel, V.; Le Bayon, I.; Ismail, R.; Federighi, M. Microbial Safety of Wood in Contact with Food: A Review. Compr. Rev. Food Sci. Food Saf. 2016, 15, 491–505. [Google Scholar] [CrossRef] [PubMed]
- Guillard, V.; Gaucel, S.; Fornaciari, C.; Angellier-Coussy, H.; Buche, P.; Gontard, N. The Next Generation of Sustainable Food Packaging to Preserve Our Environment in a Circular Economy Context. Front. Nutr. 2018, 5, 121. [Google Scholar] [CrossRef] [PubMed]
- Parker, T. ‘Six to Solve’: How Australia Could Halve the Amount of Plastic Waste Leaked into the Environment, in NS Packaging 2020: NS Packaging-Analysis. Available online: https://www.nspackaging.com/analysis/australia-plastic-waste/ (accessed on 10 February 2022).
- López-Goldar, X.; Villari, C.; Bonello, P.; Borg-Karlson, A.K.; Grivet, D.; Sampedro, L.; Zas, R. Genetic variation in the constitutive defensive metabolome and its inducibility are geographically structured and largely determined by demographic processes in maritime pine. J. Ecol. 2019, 107, 2464–2477. [Google Scholar] [CrossRef]
- Grow International—A Lightwood Packaging Sector Organisation. 2021. Available online: https://www.grow-international.eu/ (accessed on 10 February 2022).
- Filip, S.; Fink, R.; Oder, M.; Jevšnik, M. Hygienic acceptance of wood in food industry. Wood Sci. Technol. 2011, 46, 657–665. [Google Scholar] [CrossRef]
- Khademi Kord, H.; Pazirandeh, A. Comparison of Different Packaging Materials and Solutions on a Cost Basis for Volvo Logistic Corporation; University of Borås/School of Engineering: Borås, Sweden, 2008. [Google Scholar]
- Malhotra, B.; Keshwani, A.; Kharkwal, H. Antimicrobial food packaging: Potential and pitfalls. Front. Microbiol. 2015, 6, 611. [Google Scholar] [CrossRef]
- Milling, A.; Kehr, R.; Wulf, A.; Smalla, K. Survival of bacteria on wood and plastic particles: Dependence on wood species and environmental conditions. Holzforschung 2005, 59, 72–81. [Google Scholar] [CrossRef]
- Ripolles-Avila, C.; Hascoët, A.; Ríos-Castillo, A.; Rodríguez-Jerez, J. Hygienic properties exhibited by single-use wood and plastic packaging on the microbial stability for fish. LWT 2019, 113, 108309. [Google Scholar] [CrossRef]
- Siroli, L.; Patrignani, F.; Serrazanetti, D.I.; Chiavari, C.; Benevelli, M.; Grazia, L.; Lanciotti, R. Survival of Spoilage and Pathogenic Microorganisms on Cardboard and Plastic Packaging Materials. Front. Microbiol. 2017, 8, 2606. [Google Scholar] [CrossRef]
- Becerra, J.; Flores, C.; Mena, J.; Aqueveque, P.; Alarcón, J.; Bittner, M.; Hernandez, V.; Hoeneisen, M.; Ruiz, E.; Silva, M. Antifungal and antibacterial activity of diterpenes Isolated from wood extractables of chilean podocarpaceae. Boletín Soc. Chil. Química 2002, 47, 151–157. [Google Scholar] [CrossRef]
- Munir, M.T. Wood and Hospital Hygiene: Investigating the Hygienic Safety and Antimicrobial Properties of Wood Materials. Doctoral Dissertation, École Centrale de Nantes, Nantes, France, 2021; p. 226. [Google Scholar]
- Vainio-Kaila, T.; Kyyhkynen, A.; Rautkari, L.; Siitonen, A. Antibacterial Effects of Extracts of Pinus sylvestris and Picea abies against Staphylococcus aureus, Enterococcus faecalis, Escherichia coli, and Streptococcus pneumoniae. BioResources 2015, 10, 7763–7771. [Google Scholar] [CrossRef]
- Nada, A.M.A.; El-Diwany, A.I.; Elshafei, A.M. Infrared and antimicrobial studies on different lignins. Acta Biotechnol. 1989, 9, 295–298. [Google Scholar] [CrossRef]
- Dong, X.; Dong, M.; Lu, Y.; Turley, A.; Jin, T.; Wu, C. Antimicrobial and antioxidant activities of lignin from residue of corn stover to ethanol production. Ind. Crop. Prod. 2011, 34, 1629–1634. [Google Scholar] [CrossRef]
- Rautio, M.; Sipponen, A.; Peltola, R.; Lohi, J.; Jokinen, J.J.; Papp, A.; Carlson, P.; Sipponen, P. Antibacterial effects of home-made resin salve from Norway spruce (Picea abies). APMIS 2007, 115, 335–340. [Google Scholar] [CrossRef]
- Johnston, W.H.; Karchesy, J.J.; Constantine, G.H.; Craig, A.M. Antimicrobial activity of some Pacific Northwest woods against anaerobic bacteria and yeast. Phytotherapy Res. 2001, 15, 586–588. [Google Scholar] [CrossRef]
- Omar, S.; Lemonnier, B.; Jones, N.; Ficker, C.; Smith, M.; Neema, C.; Towers, G.; Goel, K.; Arnason, J. Antimicrobial activity of extracts of eastern North American hardwood trees and relation to traditional medicine. J. Ethnopharmacol. 2000, 73, 161–170. [Google Scholar] [CrossRef]
- Laireiter, C.M.; Schnabel, T.; Köck, A.; Stalzer, P.; Petutschnigg, A.; Oostingh, G.J.; Hell, M. Active Anti-Microbial Effects of Larch and Pine Wood on Four Bacterial Strains. BioResources 2013, 9, 273–281. [Google Scholar] [CrossRef]
- Munir, M.T.; Aviat, F.; Pailhories, H.; Eveillard, M.; Irle, M.; Federighi, M.; Belloncle, C. Direct screening method to assess antimicrobial behavior of untreated wood. Eur. J. Wood Wood Prod. 2019, 77, 319–322. [Google Scholar] [CrossRef]
- Vainio-Kaila, T.; Zhang, X.; Hänninen, T.; Kyyhkynen, A.; Johansson, L.-S.; Willför, S.; Österberg, M.; Siitonen, A.; Rautkari, L. Antibacterial effects of wood structural components and extractives from Pinus sylvestris and Picea abies on methicillin-resistant Staphylococcus aureus and Escherichia coli O157:H7. BioResources 2017, 12, 7601–7614. [Google Scholar] [CrossRef]
- Munir, M.T.; Pailhories, H.; Eveillard, M.; Aviat, F.; Lepelletier, D.; Belloncle, C.; Federighi, M. Antimicrobial Characteristics of Untreated Wood: Towards a Hygienic Environment. Health 2019, 11, 152–170. [Google Scholar] [CrossRef][Green Version]
- Munir, M.T.; Pailhories, H.; Eveillard, M.; Irle, M.; Aviat, F.; Dubreil, L.; Federighi, M.; Belloncle, C. Testing the Antimicrobial Characteristics of Wood Materials: A Review of Methods. Antibiotics 2020, 9, 225. [Google Scholar] [CrossRef]
- Bertaud, F.; Holmbom, B. Chemical composition of earlywood and latewood in Norway spruce heartwood, sapwood and transition zone wood. Wood Sci. Technol. 2004, 38, 245–256. [Google Scholar] [CrossRef]
- Papadopoulou, C.; Soulti, K.; Roussis, I.G. Potential antimicrobial activity of red and white wine phenolic extracts against strains of Staphylococcus aureus, Escherichia coli and Candida albicans. Food Technol. Biotechnol. 2005, 43, 41–46. [Google Scholar]
- Munir, M.; Pailhoriès, H.; Aviat, F.; Lepelletier, D.; Pape, P.; Dubreil, L.; Irle, M.; Buchner, J.; Eveillard, M.; Federighi, M.; et al. Hygienic Perspectives of Wood in Healthcare Buildings. Hygiene 2021, 1, 12–23. [Google Scholar] [CrossRef]
- Munir, M.T.; Belloncle, C.; Pailhoriès, H.; Eveillard, M.; Aviat, F.; Federighi, M. Survival of Nosocomial pathogens on Maritime pine and European fir wood. In Proceedings of the 5th International Conference on Processing Technologies for the Forest and Bio-Based Products Industries, Freising/Munich, Germany, 20–21 September 2018; pp. 213–217. [Google Scholar]
- Breijyeh, Z.; Jubeh, B.; Karaman, R. Resistance of Gram-Negative Bacteria to Current Antibacterial Agents and Approaches to Resolve It. Molecules 2020, 25, 1340. [Google Scholar] [CrossRef]
- Neely, A.N.; Maley, M.P. Survival of Enterococci and Staphylococci on Hospital Fabrics and Plastic. J. Clin. Microbiol. 2000, 38, 724–726. [Google Scholar] [CrossRef]
- Rowell, R.M. Handbook of Wood Chemistry and Wood Composites; CRC Press: Boca Raton, FL, USA, 2012. [Google Scholar]
- Pailhoriès, H.; Munir, M.T.; Aviat, F.; Federighi, M.; Belloncle, C.; Eveillard, M. Oak in Hospitals, the worst enemy of Staphylococcus aureus? Infect. Control Hosp. Epidemiol. 2017, 38, 382–384. [Google Scholar] [CrossRef]
- Munir, M.T.; Aviat, F.; Lepelletier, D.; Pape, P.L.; Dubreil, L.; Irle, M.; Federighi, M.; Belloncle, C.; Eveillard, M.; Pailhoriès, H. Wood materials for limiting the bacterial reservoir on surfaces in hospitals: Would it be worthwhile to go further? Future Microbiol. 2020, 15, 1431–1437. [Google Scholar]
Publisher’s Note: MDPI stays neutral with regard to jurisdictional claims in published maps and institutional affiliations. |
© 2022 by the author. Licensee MDPI, Basel, Switzerland. This article is an open access article distributed under the terms and conditions of the Creative Commons Attribution (CC BY) license (https://creativecommons.org/licenses/by/4.0/).